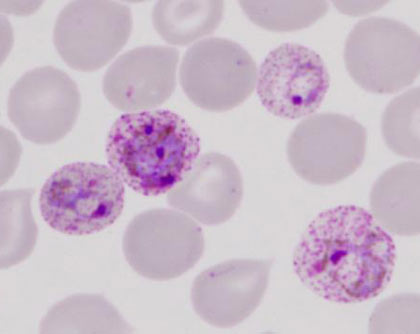

Theo Quyết định số 2331/QĐ-TTg ngày 20 tháng 12 năm 2010 của Thủ tướng Chính phủ ban hành danh mục các Chương trình mục tiêu quốc gia năm 2011, trong đó Dự án An toàn truyền máu được đưa vào một trong 7 dự án thành phần thuộc Chương trình mục tiêu quốc gia y tế để chỉ đạo triển khai nhằm góp phần trong sự nghiệp chăm sóc bảo vệ sức khỏe nhân dân. Trong an toàn truyền máu, cần chú ý sốt rét do máu truyền.
Thông điệp của Chương trình mục tiêu quốc gia y tế về an toàn truyền máu năm 2011 là sử dụng máu hợp lý, hiệu quả, nâng cao chất lượng chăm sóc, bảo vệ sức khoẻ cho người bệnh; mỗi giọt máu đưa vào cơ thể người bệnh phải là máu sạch, an toàn cho người cho máu và người được cho máu. Phòng tránh lây chéo một số bệnh do truyền máu và các chế phẩm từ máu như HIV, sốt rét, viêm gan B, viêm gan C, giang mai và nhiều yếu tố quan trọng khác…Để thực hiện an toàn truyền máu, kêu gọi mọi người cứu sống người bệnh, đảm bảo an toàn ngân hàng máu sống; số lượng máu phải được kiểm tra sàng lọc kỹ trước khi sử dụng, nâng cao công tác chăm sóc và bảo vệ sức khoẻ cho người bệnh… Các cơ sở y tế kể cả những đơn vị tiếp nhận máu cần quan tâm đến vấn đề sốt rét do truyền máu.
Trong nghiên cứu thực nghiệm, với nhiệt độ bảo quản máu ở 4 oC, ký sinh trùng sốt rét có thể tồn tại trong máu lưu trữ khoảng 15 ngày, đặc biệt khi chất chống đông có chứa dextrose. Hiện nay tình hình giao lưu, đi lại của cộng đồng người dân khá phổ biến nên nguy cơ sốt rét do truyền máu có thể tăng lên khi những người cho máu có đi du lịch hoặc đi nghỉ dưỡng, đi công tác ở các vùng sốt rét lưu hành bị nhiễm ký sinh trùng sốt rét mang về.
Khả năng tồn tại của ký sinh trùng sốt rét trong cơ thể người tùy theo từng chủng loại nếu không bị tái nhiễm lại. Chủng loại ký sinh trùng sốt rét Plasmodium falciparum có thể tồn tại từ 6 đến 8 tháng, Plasmodium vivax và Plasmodium ovale tồn tại từ 5 đến 7 năm và Plasmodium malariae có thể lên tới 30 năm nếu không được phát hiện, điều trị. Trong các vùng sốt rét lưu hành, cần kiểm tra ký sinh trùng sốt rét của những người cho máu. Trên thực tế, tại vùng duyên hải miền Tây nước Mỹ, trong cộng đồng những người chích ma túy đã xảy ra sự lây truyền sốt rét do tiêm chích ma túy dùng chung bơm kim tiêm với người mang ký sinh trùng sốt rét và đã gây nên những vụ dịch sốt rét nhỏ |
Chủng loại ký sinh trùng sốt rét Plasmodium falciparum có thể tồn tại từ 6 đến 8 tháng, Plasmodium vivax và Plasmodium ovale tồn tại từ 5 đến 7 năm và Plasmodium malariae có thể lên tới 30 năm nếu không được phát hiện, điều trị. |
Bệnh sốt rét do truyền máu có thời gian ủ bệnh thường ngắn hơn so với sốt rét thông thường. Tuy nhiên trong thực tế đã có những trường hợp bệnh nhân sốt rét do truyền máu có thời gian ủ bệnh kéo dài từ 30 đến 40 ngày, thậm chí có thể lên tới 90 ngày. Bệnh cảnh lâm sàng sốt rét do truyền máu thường xảy ra nhẹ hơn, ít tái phát; dù bị nhiễm chủng loại ký sinh trùng sốt rét Plasmodium vivax nhưng không có tái phát xa do thể ngủ ngoại hồng cầu của ký sinh trùng ở trong gan. Tuy nhiên gần đây, các nhà khoa học và y học đã phát hiện những trường hợp sốt rét do truyền máu có bệnh cảnh lâm sàng rất nặng, thậm chí có thể gây tử vong xảy ra trên bệnh nhân có thể trạng suy yếu và chẩn đoán, điều trị muộn.
Việc truyền máu có thể làm cho người bệnh bị lây các bệnh nhiễm trùng qua đường máu nguy hiểm. Đồng thời có thể gây ra các phản ứng miễn dịch nguy hiểm cho bệnh nhân, nhất là khi truyền nhầm nhóm máu và cũng có thể tạo nên các miễn dịch dị ứng trong quá trình truyền máu. Vì vậy, để thực hiện các biện pháp đảm bảo an toàn truyền máu cần tuyển chọn được người hiến máu an toàn; tăng cường chất lượng sàng lọc các loại bệnh lây theo đường máu như HIV/AIDS, viêm gan B, viêm gan C, giang mai và sốt rét tại các phòng xét nghiệm đạt tiêu chuẩn. Đồng thời chỉ định việc sử dụng hợp lý máu và các chế phẩm máu, lựa chọn được đơn vị máu tương đồng với máu của bệnh nhân, giám sát sự truyền máu ngay tại giường bệnh. Ngoài ra, có thể thực hiện truyền máu tự thân, loại bỏ bạch cầu trong đơn vị máu trước khi truyền.
Theo y văn, bệnh sốt rét có 3 nguyên nhân chính là do muỗi mang mầm bệnh ký sinh trùng sốt rét truyền, do truyền máu có ký sinh trùng sốt rét và do mẹ bị mắc bệnh sốt rét truyền sang cho con khi sinh. Nguyên nhân do muỗi truyền khá phổ biến, còn nguyên nhân do truyền máu và do mẹ truyền sang con hiếm gặp hơn. Hiện nay nhu cầu cần có một số lớn lượng máu để điều trị, cứu sống nhiều người bệnh là một vấn đề rất cấp bách. Phong trào hiến máu tình nguyện khá rầm rộ, những người bán máu cũng không ít, đối tượng hiến máu và bán máu rất đa dạng, phong phú nên việc sàng lọc máu để loại bỏ mầm bệnh và các yếu tố nguy hại khác phải được các cơ sở tiếp nhận máu thận trọng. Sốt rét do truyền máu hiếm gặp nhưng trên thực tế không phải là không có.